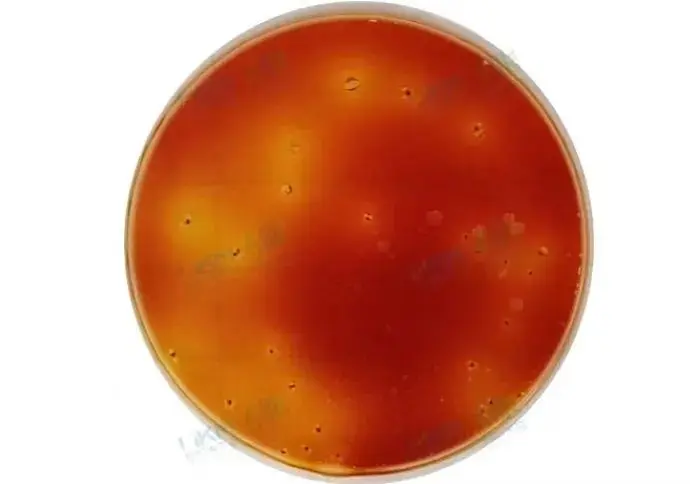
HP002大肠菌群测试片结果判读

速递!2025版GB4789.3/GB4789.30/GB4789.38标准修订亮点
发布时间:2025-03-28 浏览次数:7994
好消息!好消息!大家期待已久的《GB 4789.3-2025 食品微生物学检验 大肠菌群计数》《GB 4789.38-2025 食品微生物学检验 大肠埃希氏菌计数》《GB 4789.30-2025 食品微生物学检验 单核细胞增生李斯特氏菌检验》终于在这春暖花开的季节发布了,新标准修订内容不仅体现了国内标准与国际标准接轨的趋势,而且使标准方法操作和结果报告处理更加灵活简单又快捷。为了方便大家快速清晰地了解这些新变化,小编梳理了一下这三个标准修订内容的亮点,具体见下表:
| 标准 | 修订内容 |
|---|
| GB 4789.3-2025 大肠菌群计数 | 亮点一、创新:增加了大肠菌群测试片法,并明确测试片应以发酵乳糖产酸产气为阳性结果判断依据,且性能符合 GB4789.28 中相关培养基的质量要求。 亮点二、灵活:液体样品稀释明确了当样品不适宜进行体积取样时,按 6.1.1 固体和半固体样品称重操作。 亮点三、省时:MPN计数法 复发酵试验培养时间由“ 48h±2h ”修改为“ 24-48h ”,若最短培养时间内得到阳性结果,则检验周期可缩短 24h。 亮点四、全面: 1)在平板法 9.2 接种与培养中增加“对于乳及乳制品,应置于 30℃±1℃ 培养 18h~ 24h 。”这是基于国内外文献报道,培养温度为 30 ℃ 时乳制品中大肠菌群平板计数的结果,显著高于培养温度为 36 ℃ 的计数结果,在国外相关标准中已将乳制品中大肠菌群平板计数培养温度规定为 30 ℃ 左右,以及修标单位经调查研究和实验验证后,作出的修订。 2)明确MPN 计数法初发酵试验,如接种体积超过 1mL ,则加到等体积的双料LST肉汤中; 3)MPN 计数法初发酵试验阳性结果描述由“ 观察倒管内是否有气泡产生 ”修改为“ 小倒管或产气收集装置内有气泡产生,或轻轻振摇 LST肉汤管 可见试管内有细密气泡不断上升者,判断为产气”,更加详细明了。 4)MPN计数法 的结果与报告增加“ 附录C 确定最适的 3个连续稀释度方法”,平板法的结果与报告增加“ 附录D 规定了大肠菌群菌落数的计算、数值修约和结果报告的方式,并给出了相关示例。”,新增附录让实验结果处理变得简单。 |
| GB 4789.30-2025 单核细胞增生李斯特氏菌检验 | 亮点一、与国际接轨: 1)参照 ISO 方法和经起草组验证,将 定性检验 和 MPN法 中的选择性增菌液体培养基由 LB1 和 LB2 修改为“ Fraser增菌肉汤(FB1、FB2)”;选择分离显色培养基“李斯特氏菌显色平板“修改为“OA李斯特氏菌显色平板”并在 附录A 培养基和试剂中增加了 OA李斯特氏菌显色培养基配方。 2)参照 ISO 等国际、国家标准,将平板计数规则“ 所有平板菌落数合计在 15CFU ~ 150CFU 之间的平板,计数典型菌落数。”修改为“所有平板典型和可疑菌落数合计在 15CFU ~ 150CFU 之间的平板,计数典型和可疑菌落数。”经验证可提高结果的稳定性。 亮点二、实惠省时: 1)结合我国现行有效的与单增李斯特菌限量指标相关的标准将平板计数,“ 8.2 样品的接种 ”将原来“ 每个稀释度的样品匀液分别吸取 1mL 以 0.3mL、0.3mL、0.4mL 的接种量分别接种 3块李斯特氏菌显色平板”修改为“ 每个稀释度分别吸取 0.1mL 样品匀液,接种1个 OA李斯特氏菌显色培养基(或其他等效的李斯 特氏菌显色培养基)平板 ”,大大减少了显色培养基的用量,又能满足现行产品标准需要。同时继续保留“ 0.3mL、0.3mL、0.4mL 涂布法”,满足检出限更低的需求和方法的延续性。 2)在“ 5.5 鉴定 ”中增加“ 如选择生化鉴定试剂盒或微生物生化鉴定系统,可不经 5.4 初步鉴定,直接从 TSA-YE平板或羊血平板上挑取可疑菌落,用生理盐水制备成浊度适当的菌悬液,使用微生物生化鉴定试剂盒或微生物生化 鉴定系统进行鉴定。”结合使用生化鉴定试剂盒或微生物生化鉴定系统实际情况,优化鉴定流程,缩短检验时长。 亮点三、严谨: 1)在 8.2 样品的接种中增加“ 8.2.3 从样品稀释至样品接种完毕不得超过 45min。”避免操作时间过长影响计数结果。 2)在“ 5.2 分离 ”中增加显色培养基菌落识别注意事项(避免假阴性和假阳性结果): “注1:一些单核细胞增生李斯特氏菌在 OA李斯特氏菌显色培养基上的菌落周围的晕圈不明显甚至没有晕圈。还有一些单核细胞增生李斯特氏菌在 OA李斯特氏菌显色培养基上的菌落周围的晕圈出现得比较迟缓,有时需要 4d 以上才出现。 注2:伊氏李斯特氏菌在 OA李斯特氏菌显色培养基上的菌落形态与单核细胞增生李斯特氏菌相似。” |
| GB 4789.38-2025 大肠埃希氏菌计数 | 亮点一、与国际接轨:参考 ISO 方法和经起草组验证,将大肠埃希氏菌MPN计数中复发酵阳性管划线分离培养基 EMB 和平板计数 VRBA-MUG 修改为“ 胰蛋白胨胆盐 X-葡萄糖醛酸苷(TBX)琼脂 ”,菌落观察更加直观清晰。并删除了 MPN计数法“ 靛基质试验、MR-VP试验和柠檬酸盐利用试验 ”对分离平板上可疑菌落进行鉴定的内容,检验时长缩短至少 24h。 亮点二、严谨: 1)删除了术语和定义;增加了检验原理,并注明“ 绝大多数大肠埃希氏菌具有β-葡萄糖醛酸苷酶活性,但大肠埃希氏菌O157 等菌株没有β-葡萄糖醛酸苷酶活性。另外,肠杆菌科内一些志贺氏菌、沙门氏菌等菌株也具有β-葡萄糖醛酸苷酶活性。” 2)本新标准 MPN法中新增“ 对贝类及产品采用每个稀释度接种 5管 LST肉汤的方法。”并且新增相应“ 附录C 贝类及产品中大肠埃希氏菌最可能数(MPN)检索表”。 3)MPN计数法 初发酵试验阳性结果描述由“ 观察倒管内是否有气泡产生 ”修改为“ 小倒管或产气收集装置内有气泡产生,或轻轻振摇 LST肉汤管可见试管内有细密气泡不断上升者,判断为产气”,更加详细明了。 |
最后,环凯微生物为助力各食品微生物检验实验室轻松应对新标准更新带来的工作量和挑战,现已整理出相应产品解决方案供选择(见以下列表)!
|
|
培养:36°℃,培养24h 判读:含有四氮唑指示剂,菌落为红色,发酵乳糖产酸(黄色酸环)和产气(伴有气泡)。
|
|
|
|
|
CRM019 OA李斯特氏菌显色培养基(单增菌落:蓝绿色光滑规则小菌落,周围有乳白色脂肪沉淀环)
|
CRM018A/CRM018 胰蛋白胨胆盐X-葡萄糖醛酸苷(TBX)琼脂培养基(大肠埃希氏菌菌落:蓝绿色)
|
GB4789.3-2025 大肠菌群计数产品解决方案
GB4789.30-2025 单核细胞增生李斯特氏菌检验产品解决方案
GB4789.38-2025 大肠埃希氏菌计数产品解决方案